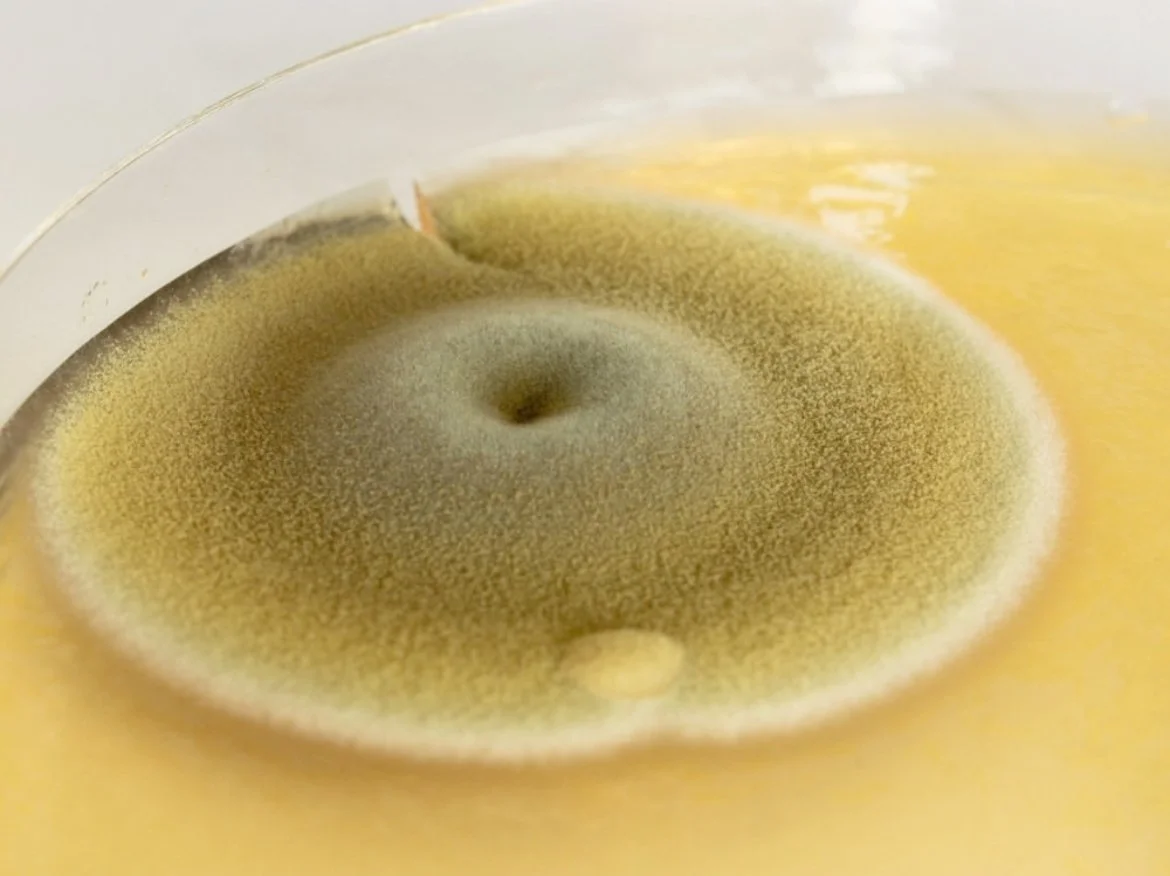

Making Time 2025 - 2026, Artangel
I’m delighted to be working alongside Nastassja Simensky, Taey Iohe & Undead Matter for the second iteration of Making Time supported by Artangel and a network of gallery and academic partners.
For more information please click here.
Image Credit: Sophie J Williamson | Undead Matter
From Waste to Resource: Circular Economies for Construction Spoil Clay
I am currently leading a 19-month research project in partnership with British Ceramics Biennial & HS2 exploring the creative re-use of clay extracted from UK construction spoil. The research project is investigating the opportunities and challenges of reusing clay sourced from UK construction spoil. Construction activity in the UK extracts thousands of tonnes of clay each year. Most of this clay is classified as waste and sent to landfill. By viewing this material as a resource rather than waste, we are exploring the potential environmental, social and economic impact this shift in thinking might achieve.
For more information please click here
Architects: Tuckey Design Studio
Photo Credit: Nick Ingram